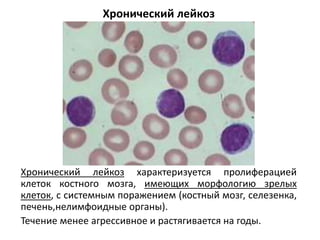
Хронический лейкоз
Хронический лейкоз характеризуется пролиферацией
клеток костного мозга, имеющих морфологию зрелых
клеток, с системным поражением (костный мозг, селезенка,
печень,нелимфоидные органы).
Течение менее агрессивное и растягивается на годы.
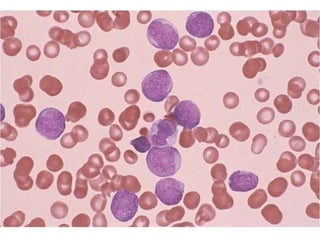

Документ подробно описывает гемобластозы, включая классификацию различных типов лейкозов и их морфологические характеристики. Основное внимание уделяется диагностическим методам, таким как морфология, цитохимическое и генетическое исследование, а также иммунофенотипирование для определения типа клеток и их дифференцировки. Лейкозы делятся на острые и хронические, каждый из которых имеет специфические прогнозы и классификации.